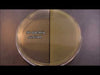

Harmonica Bug Blaster - UV Sanitizer
=THEY HAD A GOOD RUN!=
=OUT OF STOCK=
But don't dispair - you can still find many good ozone sanitizers on Amazon - marketed for smartphones, jewelry, and other harmonica-sized items.
(thank heavens that the pandemic is a distant memory)
TurboHarp's UV Light and Ozone Sterilizer combine the power of UV sterilization and ozone that is perfect for cleaning and sanitizing your harmonica and other small items. Made from durable silicone rubber, it is designed to be compact, lightweight, portable, and flexible. It features USB charging and a 5-minute sterilizing cycle. You can easily roll it up and take it with you anywhere.
Germs and bacteria love to grow in warm, moist environments ... like the nooks and crannies of your harmonica. The UV Light and Ozone Sterilizer's powerful cleaning action get deep into small cracks and crevasses. This compact and lightweight cleaner will not only sanitize your harmonicas, but it will also deodorize your harps and leave them smelling fresh... all without even getting your harp wet!
TurboDog Pledge
TurboHarp Community,
Thank You for your patience with us during the "New Website Switch"
We keep having small issues with the site, but we are doing our best to fix them as they appear!
Thank you for business!
Sincerely,
TurboDog
We currently ship to Australia, Belgium, Brazil, Canada, France, Germany,
Italy, Ireland, Netherlands, New Zealand, Singapore, South Korea, Spain, Sweden and the UK.
If you don't see your country on the list,
Email Us to inquire about shipping options.
What's New
talks about his latest
TurboHarp invention
The TuneMaster
The World's 1st Tunable Harmonica